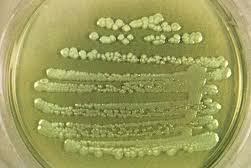
pseudomonas image

“Smells could bring a person back clearer than pictures even could.”
Ann Tyler, Breathing Lessons
Today has been one of those days where I’ve had small things to do and no ‘things’ on my schedule allowing me to be present only for me. I walked with my 15-year-old sweet dog Emmy through the woods this afternoon and her kind of walk is just perfect for a cool, spring Virginia day. We ambled through the short grasses and new forest growth beginning to overcome the path we instinctively follow. While she noticed the scents of the deer who just passed through before us, I caught a floating, familiar fragrance taking me back to my years living in SoCal.
It is unmistakable, rather sweet and grape-like but not overpowering due to the day’s cooler temperatures. The moment my nose caught this nostalgic scent my entire body stilled in the middle of the path we were walking. I was transported back to warm, sunny Oxnard, California. Many days, after work, I’d run in various spots around town and no matter where I found myself, I almost always found that wonderful  sweet grape scent dancing in the breezes. When I approached the abundantly growing Bougainvillea, I imagined the fragrance coming from its colorful, papery flowered branches reaching over the cement walls encircling the communities I ran past.
sweet grape scent dancing in the breezes. When I approached the abundantly growing Bougainvillea, I imagined the fragrance coming from its colorful, papery flowered branches reaching over the cement walls encircling the communities I ran past.
There were other plantings boasting colorful blooms atop tall stems that I encountered throughout the week. I wondered if they perhaps offered up this delicious scent that became a welcomed addition and eventual expectation to my daily run.
When running through the strawberry fields off Victoria Avenue I never encountered this rich, full scent but felt I should because of the sweet and juicy fruit growing in rows at my feet, guiding me for miles of uninterrupted, mindless running in the low afternoon sun. It did come and go as I wove throughout the small neighborhoods of Hollywood Beach, the community across the harbor from mine. From where this glorious scent actually erupted I never knew for sure, but I always without doubt find myself returning to my home by the water whenever I get a chance encounter with this memory evoking aroma so soft and sweet it needs a name.
Unfortunately, I do think I know its name…P. aeruginosa, or Pseudomonas for short. For any of you medical technologist reading this you will so identify with the grape-like smell I describe as it is one you never forget once first meeting in microbiology class. I remember when we as students first learned about this gram-negative bacteria and its distinct characteristics. It seemed to be anywhere…walking to class through one particular alleyway (ie, shortcut for our running late mornings!) we young med techs detected Pseudomonas wafting from the sewer grates dispersed along the cobbled passageway. We quickly passed through while holding our breaths to outrun the respiratory chokehold most certainly to befall us should we linger too long.
of you medical technologist reading this you will so identify with the grape-like smell I describe as it is one you never forget once first meeting in microbiology class. I remember when we as students first learned about this gram-negative bacteria and its distinct characteristics. It seemed to be anywhere…walking to class through one particular alleyway (ie, shortcut for our running late mornings!) we young med techs detected Pseudomonas wafting from the sewer grates dispersed along the cobbled passageway. We quickly passed through while holding our breaths to outrun the respiratory chokehold most certainly to befall us should we linger too long.
And now my mind conjures up the steam emitting smokestacks from another building we passed while walking to ‘THE PIT’, our affectionate name for our laboratory/classroom building. We somehow convinced ourselves we were passing through the back recesses of the hospital where unclaimed bodies from the morgue were incinerated and no matter how we timed ourselves that tall, red bricked chimney spewed forth her heated, steamy emissions just as we passed underneath. And that was the smell…hot steam. Again, we did not breath for fear of taking in more unwanted contents that might take us down another undesirable respiratory fate! I do not remember my microbiology professor, beloved by all, discrediting our fears about the Pseudomonas or the incinerator breathing building but wonder if he, too, liked a good scare? School in the city was treacherous, no?
Well this certainly did not go where I thought it might but reminiscing earlier days for this E’ville Woman was a great way to slow down and catch up with myself. Right now as I sit on my porch typing out my thoughts the scent of hickory, burning something is adrift in the air reminding me of a long ago Pittsburgh September day. One of my first outings with my daughter, before my son was born, took us exploring the Penn Colony Festival. I remember there were open firepits burning and that heady, smokey smell carried me all the way back to my Virginia home, ice skating on the frozen lakes in mid-winter with nothing but the bondfire and our teen aged friendships to keep us warm…


A wonderful journey through the smells and their small anchors in memory ..
LikeLiked by 1 person
Thank you for reading and understanding the memory triggers associated with our olfactory center. As you suggest some smells can be grounding. Hope you have a wonderful day!
LikeLike